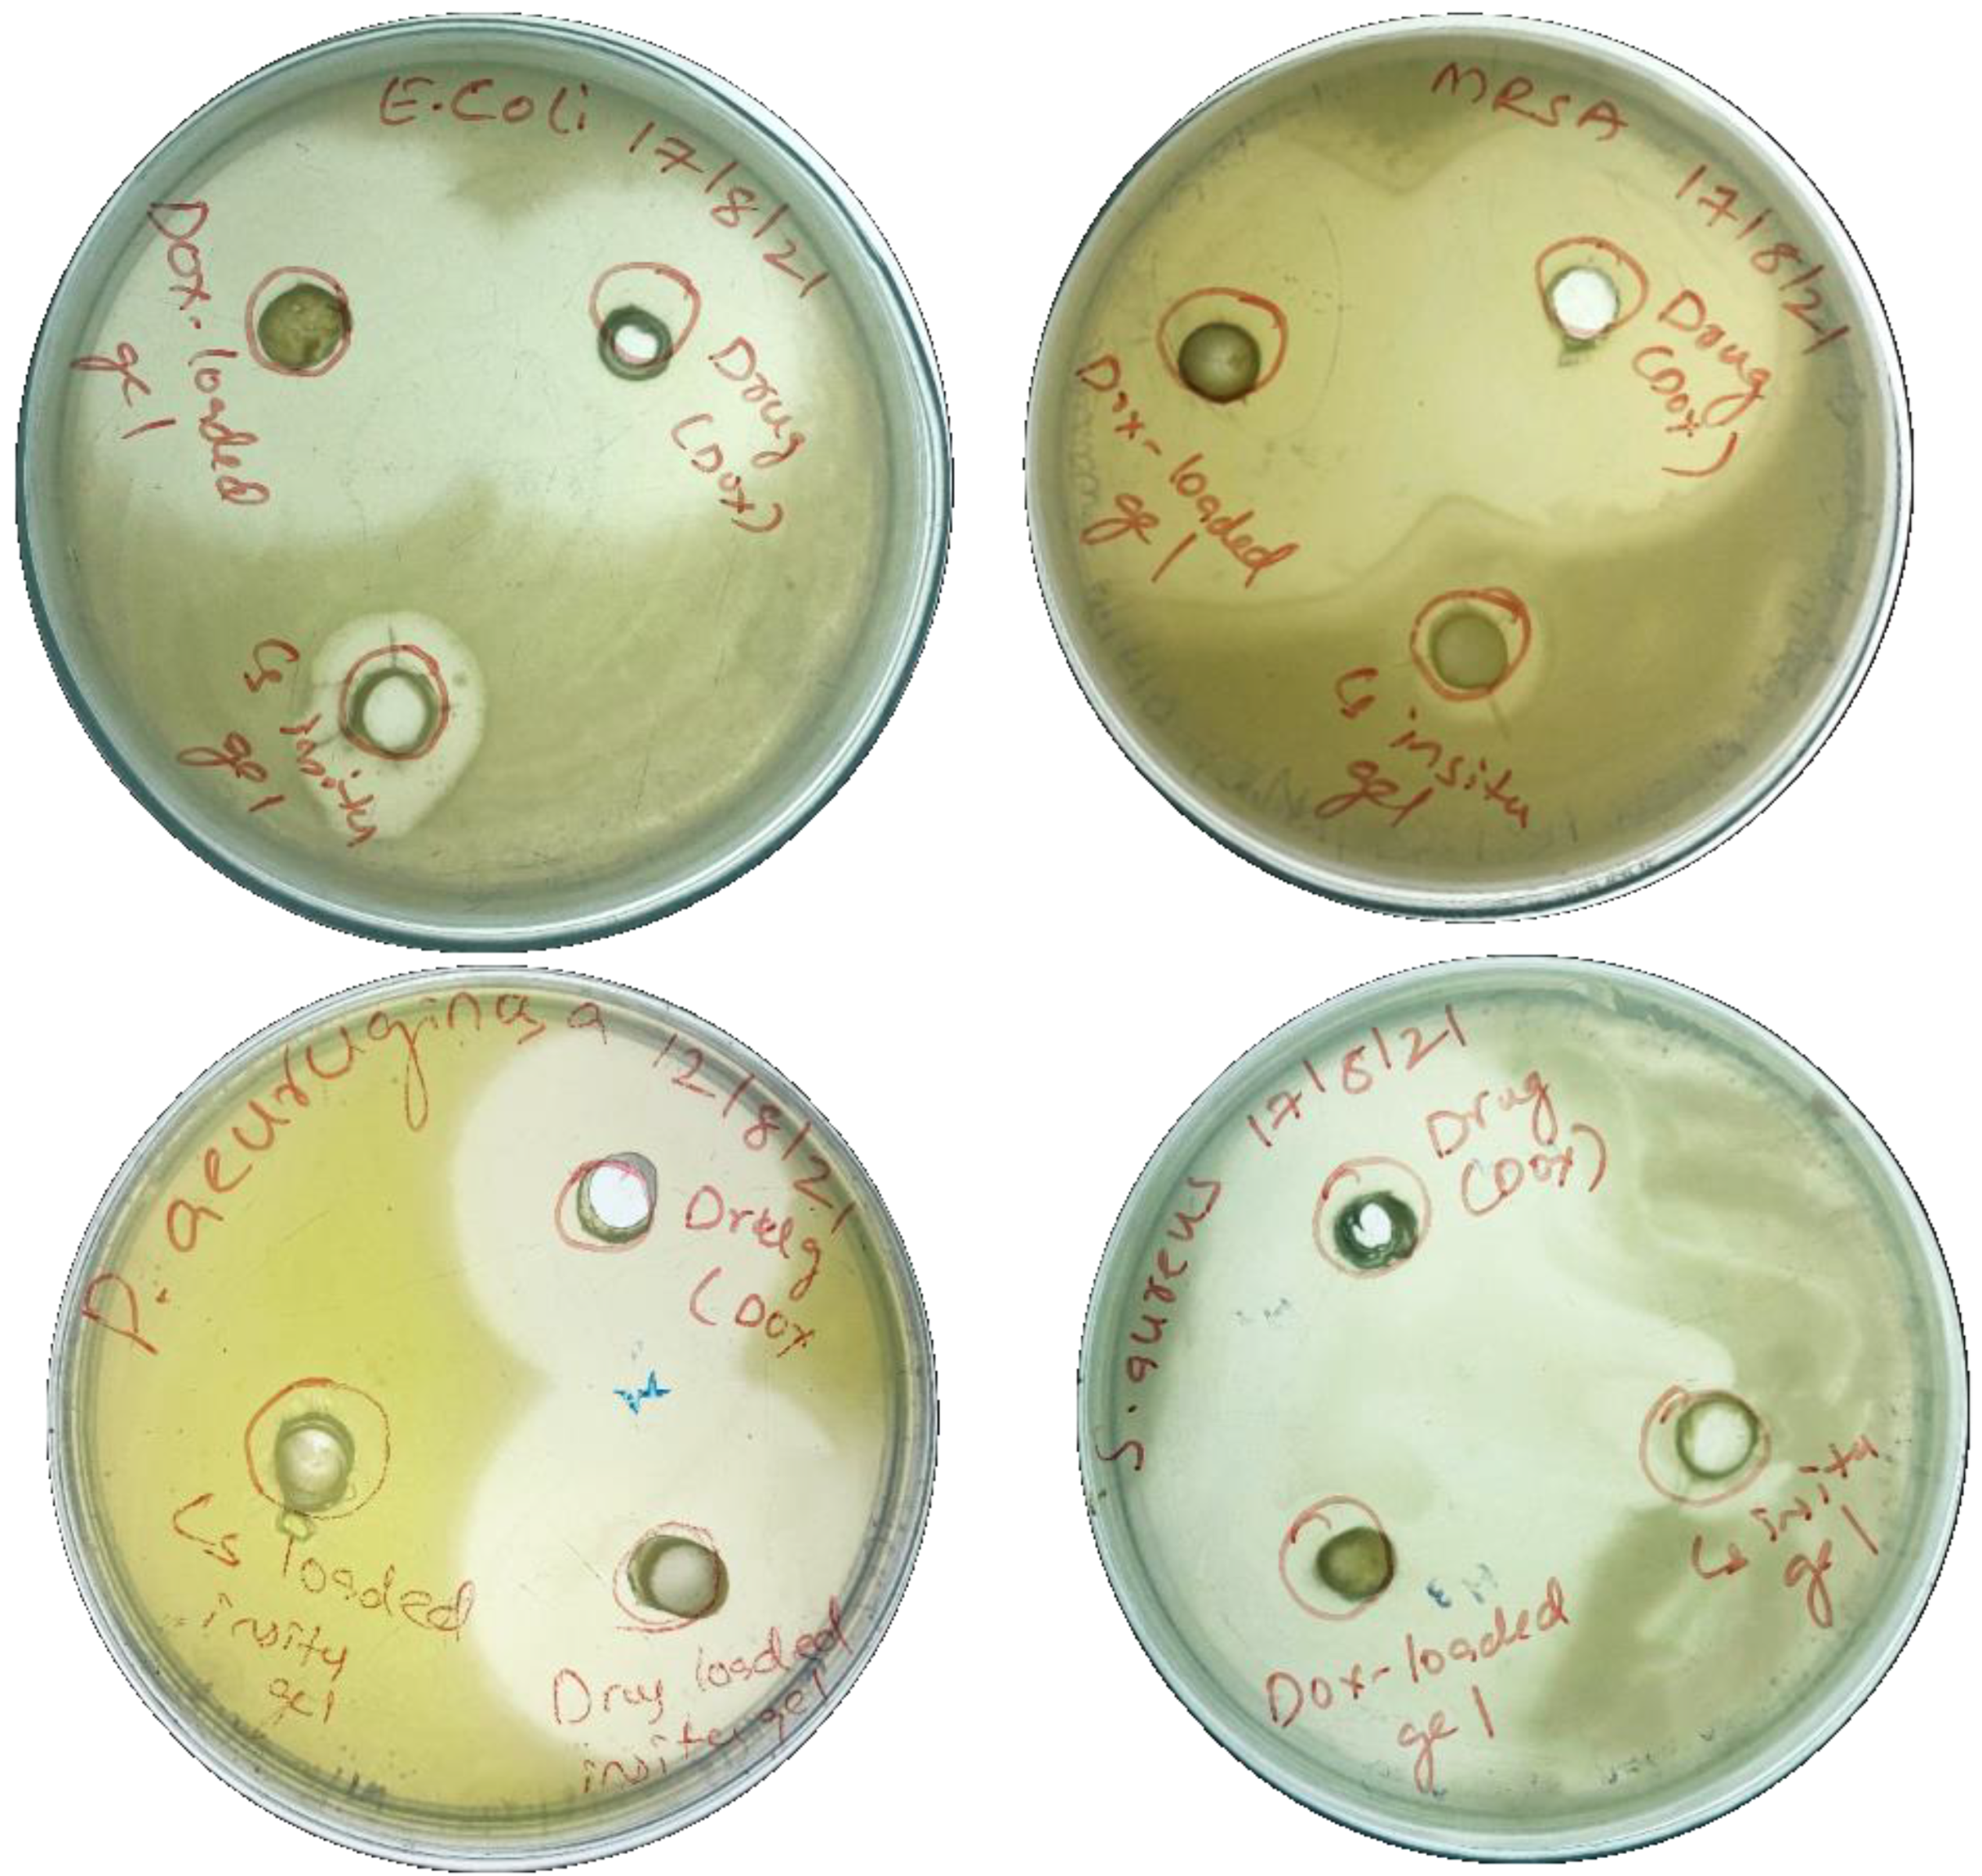
Gels 09 00027 g011 Gels 09 00027 g011

Growth Factor Loaded Thermo-Responsive Injectable Hydrogel for Enhancing Diabetic Wound Healing
Abstract
1. Introduction
2. Results and Discussion
2.1. Characterization of EGF-CS NPs
2.2. Preparation and Characterization of C-EGF-D IHG
2.3. In Vitro Evaluation
2.3.1. Analysis of Cytotoxicity Studies
2.3.2. Anti-Bacterial Activity
2.3.3. Cell Migration Assay
2.4. In Vivo Evaluation
2.4.1. Wound Healing Activity
2.4.2. Histopathology Analysis
2.4.3. MMP-9 Estimation
2.4.4. TNF-α and IL-10 Determination
3. Conclusions
4. Materials and Methods
4.1. Preparation and Characterization of EGF-Loaded Chitosan Nanoparticles (EGF-CSNPs)
4.1.1. Particle Size Determination and Zeta Potential
4.1.2. Entrapment Efficiency (EE)
4.1.3. Morphological Characterization
4.2. Preparation and Characterization of Chitosan-EGF- Doxycycline Loaded Thermo-Responsive Injectable Hydrogel (C-EGF-D IHG)
4.2.1. Morphology
4.2.2. Rheological Characterization and Injectability
4.2.3. In Vitro Drug Release Studies
4.3. Characterization of In Vitro Degradation of Formulations
4.4. In Vitro Analysis
4.4.1. Cytotoxicity Study
4.4.2. Anti-Bacterial Activity
4.4.3. Cell Migration
4.5. In Vivo Wound Healing Studies
4.5.1. Induction of Diabetes
4.5.2. Induction of Excision Wound
4.5.3. Treatment of Diabetic Excision Wound
4.5.4. Measurement of the Wound Healing
4.6. Ex Vivo Studies
4.6.1. Histopathology Studies
4.6.2. MMP-9 Estimation
4.6.3. TNF-α and Interleukin (IL)-10 Determination
4.6.4. Statistical Analysis
Author Contributions
Funding
Institutional Review Board Statement
Informed Consent Statement
Data Availability Statement
Acknowledgments
Conflicts of Interest
References
- Vazquez, J.; Short, B.; Findlow, A.H.; Nixon, B.P.; Boulton, A.J.; Armstrong, D.G. Outcomes of hyaluronan therapy in diabetic foot wounds. Diabetes Res. Clin. Pract. 2003, 59, 123–127. [Google Scholar] [CrossRef]
- Ma, H.; Peng, Y.; Zhang, S.; Zhang, Y.; Min, P. Effects and Progress of Photo-Crosslinking Hydrogels in Wound Healing Improvement. Gels 2022, 8, 609. [Google Scholar] [CrossRef] [PubMed]
- Ren, Y.; Zhang, D.; He, Y.; Chang, R.; Guo, S.; Ma, S.; Yao, M.; Guan, F. Injectable and antioxidative HT/QGA hydrogel for potential application in wound healing. Gels 2021, 7, 204. [Google Scholar] [CrossRef] [PubMed]
- Hajimiri, M.; Shahverdi, S.; Esfandiari, M.A.; Larijani, B.; Atyabi, F.; Rajabiani, A.; Dehpour, A.R.; Amini, M.; Dinarvand, R. Preparation of hydrogel embedded polymer-growth factor conjugated nanoparticles as a diabetic wound dressing. Drug Dev. Ind. Pharm. 2016, 42, 707–719. [Google Scholar] [CrossRef] [PubMed]
- Dumville, J.C.; O’Meara, S.; Deshpande, S.; Speak, K. Hydrogel dressings for healing diabetic foot ulcers. Cochrane Database Syst. Rev. 2013, 2013, CD009101. [Google Scholar] [CrossRef]
- Harding, K.; Jones, V.; Price, P. Topical treatment: Which dressing to choose. Diabetes/Metab. Res. Rev. 2000, 16, S47–S50. [Google Scholar] [CrossRef]
- Morton, L.M.; Phillips, T.J. Wound healing update. Semin. Cutan. Med. Surg. 2012, 31, 33–37. [Google Scholar] [CrossRef]
- Morin, R.J.; Tomaselli, N.L. Interactive dressings and topical agents. Clin. Plast. Surg. 2007, 34, 643–658. [Google Scholar] [CrossRef]
- Bello, Y.M.; Falabella, A.F.; Eaglstein, W.H. Tissue-engineered skin. Am. J. Clin. Dermatol. 2001, 2, 305–313. [Google Scholar] [CrossRef]
- Kamoun, E.A.; Kenawy, E.-R.S.; Chen, X. A review on polymeric hydrogel membranes for wound dressing applications: PVA-based hydrogel dressings. J. Adv. Res. 2017, 8, 217–233. [Google Scholar] [CrossRef]
- Wichterle, O.; Lim, D. Hydrophilic gels for biological use. Nature 1960, 185, 117–118. [Google Scholar] [CrossRef]
- Van Bemmelen, J. The hydrogel and the crystalline hydrate of copper oxide. Z. Anorg. Allg. Chem. 1894, 5, 466. [Google Scholar] [CrossRef]
- Peppas, N.A.; Hilt, J.Z.; Khademhosseini, A.; Langer, R. Hydrogels in biology and medicine: From molecular principles to bionanotechnology. Adv. Mater. 2006, 18, 1345–1360. [Google Scholar] [CrossRef]
- Lee, K.Y.; Mooney, D.J. Alginate: Properties and biomedical applications. Prog. Polym. Sci. 2012, 37, 106–126. [Google Scholar] [CrossRef]
- Sivashanmugam, A.; Kumar, R.A.; Priya, M.V.; Nair, S.V.; Jayakumar, R. An overview of injectable polymeric hydrogels for tissue engineering. Eur. Polym. J. 2015, 72, 543–565. [Google Scholar] [CrossRef]
- Elisseeff, J.; Anseth, K.; Sims, D.; McIntosh, W.; Randolph, M.; Langer, R. Transdermal photopolymerization for minimally invasive implantation. Proc. Natl. Acad. Sci. USA 1999, 96, 3104–3107. [Google Scholar] [CrossRef]
- Lee, C.-H.; Hung, K.-C.; Hsieh, M.-J.; Chang, S.-H.; Juang, J.-H.; Hsieh, I.-C.; Wen, M.-S.; Liu, S.-J. Core-shell insulin-loaded nanofibrous scaffolds for repairing diabetic wounds. Nanomed. Nanotechnol. Biol. Med. 2020, 24, 102123. [Google Scholar] [CrossRef]
- Davis, S.C.; Martinez, L.; Kirsner, R. The diabetic foot: The importance of biofilms and wound bed preparation. Curr. Diabetes Rep. 2006, 6, 439–445. [Google Scholar] [CrossRef]
- Clayton, W.; Elasy, T.A. A review of the pathophysiology, classification, and treatment of foot ulcers in diabetic patients. Clin. Diabetol. 2009, 10, 209–216. [Google Scholar] [CrossRef]
- Lee, Y.-H.; Hong, Y.-L.; Wu, T.-L. Novel silver and nanoparticle-encapsulated growth factor co-loaded chitosan composite hydrogel with sustained antimicrobility and promoted biological properties for diabetic wound healing. Mater. Sci. Eng. C 2021, 118, 111385. [Google Scholar] [CrossRef]
- Gainza, G.; Bonafonte, D.C.; Moreno, B.; Aguirre, J.J.; Gutierrez, F.B.; Villullas, S.; Pedraz, J.L.; Igartua, M.; Hernandez, R.M. The topical administration of rhEGF-loaded nanostructured lipid carriers (rhEGF-NLC) improves healing in a porcine full-thickness excisional wound model. J. Control. Release 2015, 197, 41–47. [Google Scholar] [CrossRef] [PubMed]
- Lai, H.-J.; Kuan, C.-H.; Wu, H.-C.; Tsai, J.-C.; Chen, T.-M.; Hsieh, D.-J.; Wang, T.-W. Tailored design of electrospun composite nanofibers with staged release of multiple angiogenic growth factors for chronic wound healing. Acta Biomater. 2014, 10, 4156–4166. [Google Scholar] [CrossRef] [PubMed]
- Karri, V.V.S.R.; Kuppusamy, G.; Talluri, S.V.; Mannemala, S.S.; Kollipara, R.; Wadhwani, A.D.; Mulukutla, S.; Raju, K.R.S.; Malayandi, R. Curcumin loaded chitosan nanoparticles impregnated into collagen-alginate scaffolds for diabetic wound healing. Int. J. Biol. Macromol. 2016, 93, 1519–1529. [Google Scholar] [CrossRef] [PubMed]
- Sanapalli, B.K.R.; Kannan, E.; Balasubramanian, S.; Natarajan, J.; Baruah, U.K.; Karri, V.V.S.R. Pluronic lecithin organogel of 5-aminosalicylic acid for wound healing. Drug Dev. Ind. Pharm. 2018, 44, 1650–1658. [Google Scholar] [CrossRef]

| Formulation | Chitosan | TPP | Ratio | Drug | Results |
|---|---|---|---|---|---|
| F1 | 0.1% | 0.1% | 1:1 | - | No opalescence observed (no formation of particles) |
| F2 | 0.6% | 0.2% | 3:1 | - | Size: 783 nm Zeta: +20 mV |
| F3 | 0.6% | 0.1% | 6:1 | - | Size: 185 nm Zeta: +21.3 mV |
| F4 | 0.2% | 0.8% | 1:4 | - | Larger particles agglomeration |
| F5 | 0.8% | 0.1% | 1:8 | - | Size: 589 nm Zeta: +13 mV |
| F6 | 0.2% | 0.4% | 1:2 | - | Particles not formed |
| F7 | 0.6% | 0.1% | 6:1 | 50 ug | Size: 201.3 nm Zeta: +28.5 mV |
| Strain | % Bacteria Isolated from DFIs |
|---|---|
| S.aureus (Gram positive) | 38 |
| P.aeruginosa (Gram negative) | 17 |
| E.coli (Gram-negative) | 11 |
| MRSA (Gram-positive) | 05 |
| Sl. No. | Name of the Bacilli | Diameter of Zone of Inhibition (cms) | ||
|---|---|---|---|---|
| DOX (Free Drug) | DOX- IHG | CS IHG | ||
| 1. | E. coli | 3.59 ± 0.17 | 4.20 ± 0.3 | 1.61 ± 0.52 |
| 2. | MRSA | 4.36 ± 0.37 | 4.76 ± 0.53 | - |
| 3. | P. aeruginosa | 3.48 ± 0.15 | 4.15 ± 0.47 | - |
| 4. | S. aureus | 3.89 ± 0.24 | 4.51 ± 0.36 | - |
Disclaimer/Publisher’s Note: The statements, opinions and data contained in all publications are solely those of the individual author(s) and contributor(s) and not of MDPI and/or the editor(s). MDPI and/or the editor(s) disclaim responsibility for any injury to people or property resulting from any ideas, methods, instructions or products referred to in the content. |
© 2022 by the authors. Licensee MDPI, Basel, Switzerland. This article is an open access article distributed under the terms and conditions of the Creative Commons Attribution (CC BY) license (https://creativecommons.org/licenses/by/4.0/).
Share and Cite
Tallapaneni, V.; Mude, L.; Pamu, D.; Palanimuthu, V.R.; Magham, S.V.; Karri, V.V.S.R.; Parvathaneni, M. Growth Factor Loaded Thermo-Responsive Injectable Hydrogel for Enhancing Diabetic Wound Healing. Gels 2023, 9, 27. https://doi.org/10.3390/gels9010027
Tallapaneni V, Mude L, Pamu D, Palanimuthu VR, Magham SV, Karri VVSR, Parvathaneni M. Growth Factor Loaded Thermo-Responsive Injectable Hydrogel for Enhancing Diabetic Wound Healing. Gels. 2023; 9(1):27. https://doi.org/10.3390/gels9010027
Chicago/Turabian StyleTallapaneni, Vyshnavi, Lavanya Mude, Divya Pamu, Vasanth Raj Palanimuthu, Sai Varshini Magham, Veera Venkata Satyanarayana Reddy Karri, and Madhukiran Parvathaneni. 2023. "Growth Factor Loaded Thermo-Responsive Injectable Hydrogel for Enhancing Diabetic Wound Healing" Gels 9, no. 1: 27. https://doi.org/10.3390/gels9010027
APA StyleTallapaneni, V., Mude, L., Pamu, D., Palanimuthu, V. R., Magham, S. V., Karri, V. V. S. R., & Parvathaneni, M. (2023). Growth Factor Loaded Thermo-Responsive Injectable Hydrogel for Enhancing Diabetic Wound Healing. Gels, 9(1), 27. https://doi.org/10.3390/gels9010027

